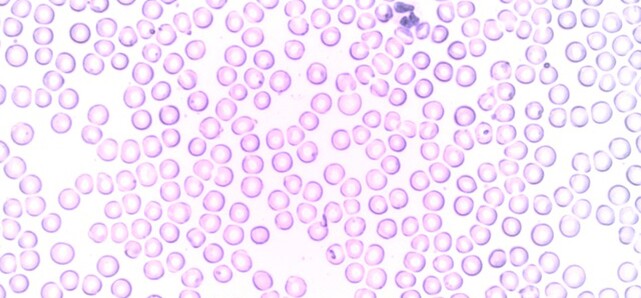

Helpful information about blood tests and why they are so important for children going through cancer treatment.
What are blood tests for?
Chemotherapy works by killing cells that grow quickly, such as cancer cells. However, it also kills other good cells that are growing fast, such as blood cells that grow in bone marrow.
Your child's healthcare team will order regular blood tests to find out if they need to treat a low blood count and to know when it is safe to give the next dose of chemotherapy.
Your child may not have to go to the hospital for every blood test. Sometimes they can be done in your local community laboratory.
Red blood cells
Red blood cells contain haemoglobin (Hb), which carries oxygen from the lungs to the rest of the body. Haemoglobin levels reveal how many red blood cells there are.
When the haemoglobin level is low, this is called anaemia. Your child may look pale, feel tired, dizzy or be short of breath. Call the hospital if you see these signs or if you are concerned.
When your child's haemoglobin is low, they may need to go to the hospital for a blood transfusion. After a transfusion, your child will look less pale and have more energy.
White blood cells
White blood cells fight infection. The most important white cells are called neutrophils. They fight bacterial infections. When the neutrophil count is low, this is called neutropaenia.
If your child's neutrophil level is low, they will be at risk of getting a serious bacterial infection.
If your child has a temperature of 38 degrees Celsius or above, you must call the hospital immediately. Your child needs medical attention.
Platelets
Some signs that your child has a low platelet count are:
- increased bruising
- nose bleeds
- bleeding gums
- tiny red spots that suddenly appear on the skin (these are small bruises)
If your child has a temperature of 38 degrees Celsius or above you must call the hospital immediately. Your child needs medical attention.
Click Donate to fund the ongoing development of the Circulating Tumor DNA project which will improve outcomes for those children already diagnosed with cancer.
Disclaimer - Content on this blog is for educational use only. Please consult your doctor or other health professional to make sure the information is right for your child.
Copyright - Please note that the information on this blog is copyright owned by The Paediatric Society of New Zealand and Starship Foundation. See copyright information at the Kids Health website.